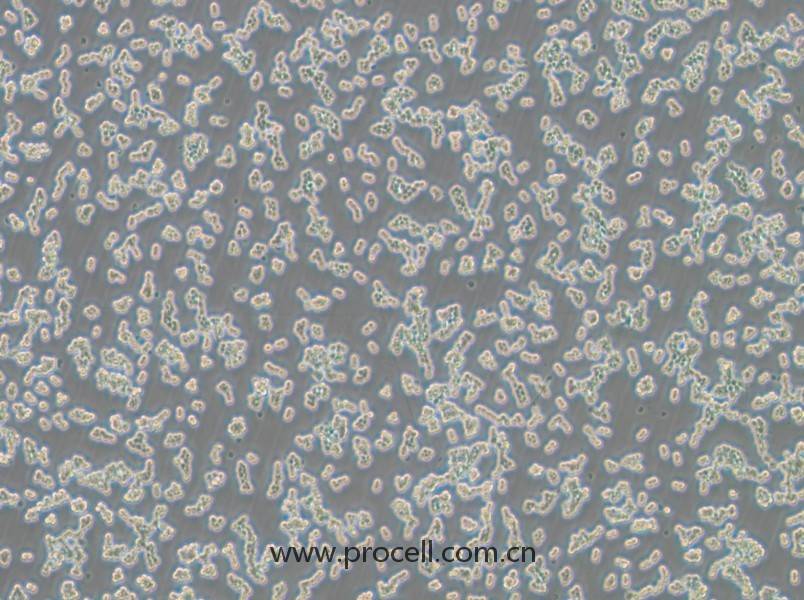
RAW 264.7-LUC (小鼠單核巨噬細胞白血病細胞（熒光素酶標記）) (STR鑒定正確)
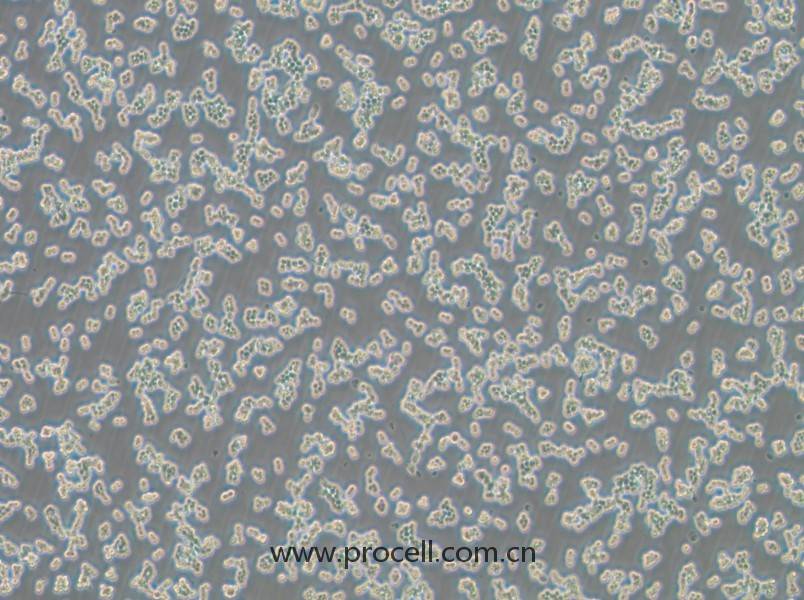
RAW 264.7-LUC (小鼠單核巨噬細胞白血病細胞（熒光素酶標記）) (STR鑒定正確)

產(chǎn)品中心Cell Resources
聯(lián)系我們CONTACT US
400-999-210024小時服務熱線
產(chǎn)品概述
| 名稱 | RAW 264.7-LUC (小鼠單核巨噬細胞白血病細胞(熒光素酶標記)) (STR鑒定正確) |
| 種屬 | 小鼠 |
| 生長特性 | 貼壁細胞,不用胰酶消化 |
| 細胞形態(tài) | 不規(guī)則形 |
| 凍存條件 | 凍存液:90% FBS+10% DMSO 溫度:液氮 |
| 培養(yǎng)方案A(默認) |
培養(yǎng)條件:
氣相:空氣,95%;CO2,5%, 溫度:37℃
|
| 推薦傳代比例 | 1:3-1:6 |
| 推薦換液頻率 | 2-3次/周 |
| 注意事項 | 1.該細胞不建議使用胰酶消化,胰酶會刺激分化;2.超過3天不傳代細胞容易分化;3.培養(yǎng)時,存在少量分化細胞,屬于正?,F(xiàn)象。 |
| 背景描述 | 熒光素酶(Luciferase)是生物體內(nèi)具有催化熒光素或脂肪醛氧化發(fā)光的一類酶的總稱,目前科研中最常用的是螢火蟲熒光素酶,該酶能催化D2熒光素氧化脫羧,產(chǎn)生激活態(tài)的氧化熒光素,發(fā)出偏紅色的生物熒光。由于熒光素酶是靠酶和底物的相互反應發(fā)光,具有特異性強、靈敏度和信噪比高,以及產(chǎn)生的生物熒光組織穿透能力強等特點。 RAW 264.7-LUC細胞是通過慢病毒轉(zhuǎn)染的方法在RAW 264.7細胞的基礎(chǔ)上構(gòu)建的,能夠長期穩(wěn)定高表達螢火蟲熒光素酶的穩(wěn)轉(zhuǎn)細胞株。該細胞株代次低、活性高、狀態(tài)好,可直接用于活體細胞注射,可進行轉(zhuǎn)錄因子調(diào)控機制研究、活體成像、細胞示蹤等實驗。半藥濃度 Puro=3.0 μg/mL。 |
| 年齡(性別) | 雄性,成年 |
| 組織來源 | Abelson鼠科白血病病毒誘導的腫瘤;單核細胞;巨噬細胞 |
| 細胞類型 | 腫瘤細胞 |
| 腫瘤類型 | 白血病細胞 |
| 生物安全等級 | BSL-2 |
| 倍增時間 | ~12-30 hours |
| 保藏機構(gòu) | Hysigen; TCM-C766L |
STR鑒定
-
STR位點信息
18-3 17,18 6-7 12 5-5 13,14 X-1 24 1-2 17 7-1 25.2 8-1 13 1-1 16 19-2 14 15-3 22.3 12-1 16 6-4 18 4-2 22.3 3-2 14 2-1 16 13-1 16.2
11-2 16,17 17-2 14,16 -
STR鑒定圖
-
FAQs
Q:{{item.question}}
A:
產(chǎn)品資料
識別碼示意圖